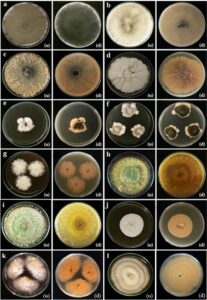
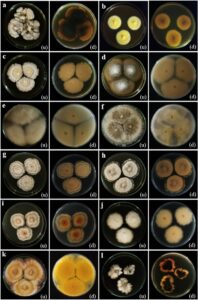
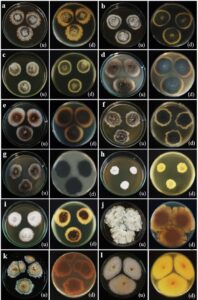

Title 01








Title 02



Title 03

Title 04

Title 05


×
![]()
